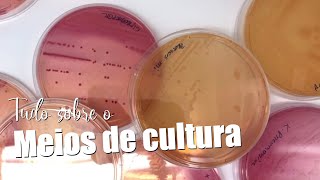
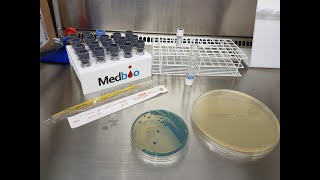

Unknown
0 views2 WordsCopy TextShare
Unknown
Video Transcript:
No transcript available.
Related Videos

19:41
Provas bioquímicas para identificação de E...
Morfo Rangers
13,845 views

1:58:50
Curso Gratuito de Identificação Bioquímica...
João Marcelo Oliveira
1,327 views

10:21
Três meios de cultura usados na MICROBIOLO...
João Marcelo Oliveira
7,695 views

13:13
Identificação de Enterobactérias
João Marcelo Oliveira
38,414 views

15:02
O mercado de trabalho para analistas clíni...
João Marcelo Oliveira
340 views

21:22
China: innovations, energy bets, silent re...
UOL
69,025 views

56:38
Microbiologia Médica: Enterokit B - Identi...
CS Ciências da Saúde
6,688 views

1:18:37
Provas de identificação bactérias gram neg...
Professora Nathália Abreu
10,032 views

2:05:21
Curso Gratuito de Identificação Bioquímica...
João Marcelo Oliveira
546 views
6:25
Por que as bactérias crescem de cores dife...
João Marcelo Oliveira
868 views

11:49
Como fazer e interpretar o Antibiograma?
João Marcelo Oliveira
112,353 views

17:59
Bactérias Gram Positivas e Gram Negativas ...
Dr. Akadêmico UFRGS
35,624 views

49:03
Provas Bioquímicas em Microbiologia
Eduardo Garrido
14,055 views

15:41
'Fui terapeuta de assassinos por 30 anos e...
BBC News Brasil
70,329 views

18:11
Tipos de Meios de Cultura Empregados na Mi...
IBAP Cursos
98,216 views

6:05
School questions celiac child's snack and ...
UOL
36,172 views

14:51
Esta CAPIVARA é uma ARTE da ENGENHARIA!
Manual do Mundo
378,541 views
27:12
Identificação bacteriana do começo ao fim
Laboratório Microanálises - Viviane Castro
5,176 views

12:40
Estrutura e Classificação dos Fungos - Mic...
Mundo Microbiologia
25,138 views

8:00
Coloração de Gram: Bactérias Gram-positiva...
Bio Aulas - Prof. Matheus Moura
216,216 views